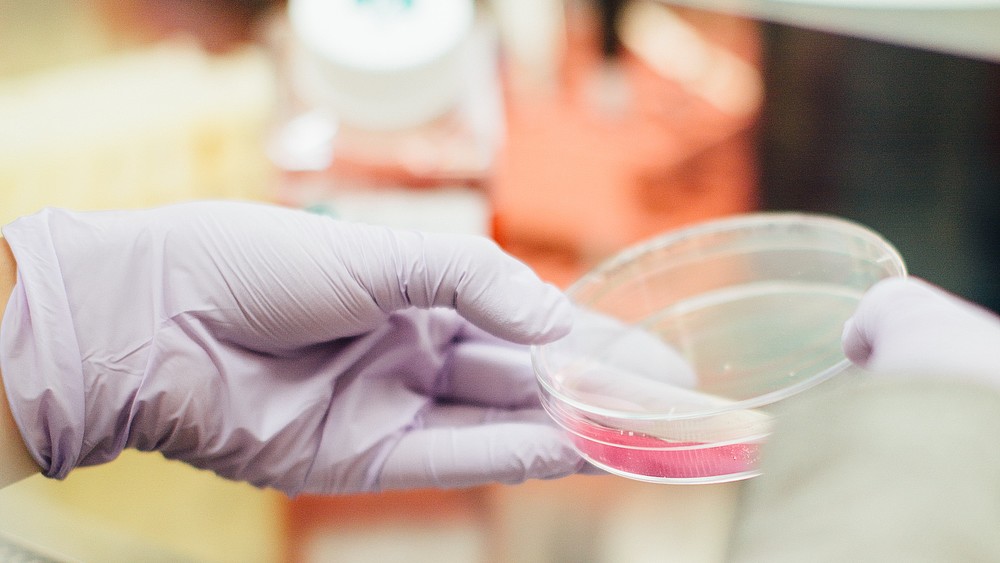
Ein spannender Exkurs in die Bereiche der Bioverfahrenstechnik

Im März 2019 endete am iTN das Teilprojekt EUROPURE MechanoSort. Ein spannender Exkurs in die Bereiche der Bioverfahrenstechnik.
Im März 2019 endete am iTN das Teilprojekt EUROPURE MechanoSort, des EFRE-geförderten Forschungsprojektes, dessen Ziel es war, unter der Anwendung von Prozessen der klassischen mechanischen Verfahrenstechnik einen kontinuierlichen Prozess zur Abtrennung von Zellkernen aus tierischem Gewebe zur Weiterverarbeitung in der Biotechnologie bereit zu stellen.
Mit diesem Teilprojekt hat die Projektgruppe Verfahrensentwicklung des iTN ihr Betätigungsfeld im Bereich des Recyclings und der Bodenaufbereitung verlassen und einen spannenden Exkurs in die Bereiche der Bioverfahrenstechnik unternommen.
Nach Charakterisierung der biogenen Materialien (Abbildung 1) wurden verschiedene Verfahren zur Dichtetrennung untersucht. Für die turbulente Hydroquerstromsortierung wurde in Zusammenarbeit mit der Firma EUROIMMUN in Rennersdorf für diesen Spezialfall ein Hydrozyklon konstruiert und gefertigt. Im Rahmen der Trennung im Zentrifugalfeld wurden verschiedene Laborzentrifugen getestet. Am Ende der Entwicklungen steht nun ein kontinuierlicher Prozess in einer Dekanterzentrifuge zur Verfügung. Die Ergebnisse der verschiedenen Prozessstufen sind in Abbildung 2 und Abbildung 3 für den ersten und dritten Aufreinigungsschritt dargestellt. Das Produkt Pellet 3 wird anschließend von den Projektpartnern weiter aufgereinigt und weiterverarbeitet.
Eine besondere technische Herausforderung war die Übertragung aus dem Labormaßstab mit Volumina weniger Milliliter hin zu einem Maßstab, in dem Volumina von einigen Litern prozessiert werden.
Im Labor des iTN steht nun eine Dekantierzentrifuge der Firma Lemitec (Abbildung 4) zur Verfügung. Diese kann Volumenströme von 30 l/h verarbeiten und die Abmessungen und Kenngrößen der Zentrifuge entsprechen den Vorgaben für den technischen Einsatz, sodass die gewonnenen Ergebnisse aus dem Labor in die Praxis übertragen werden können. Ebenso wurden aus den Projektgeldern ein Laserbeugungsspektrometer mit Nassdispergiereinheit und ein Strömungspotentiometer beschafft. An dieser Stelle sei dem Technischen Einkauf und der Abteilung Projektverwaltung für die konstruktive und zielführende Zusammenarbeit gedankt.
Das Teilprojekt ist Bestandteil des Verbundprojektes mit der Fachgruppe molekulare Biotechnologie der Fakultät Natur- und Umweltwissenschaften und der Firma EUROIMMUN Medizinische Labordiagnostika AG.

